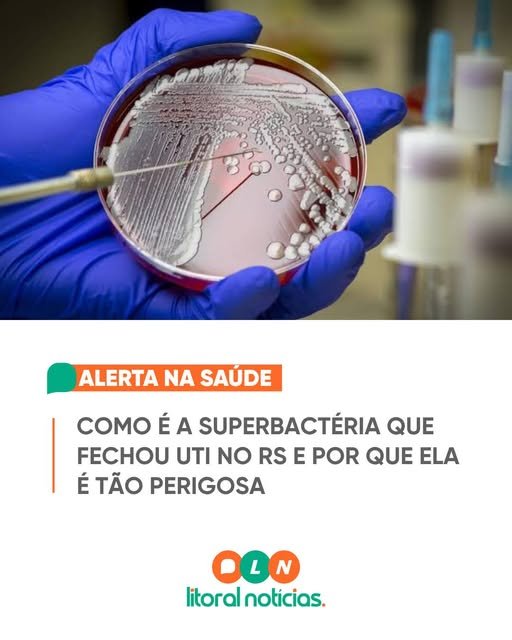

O Hospital Fêmina, em Porto Alegre, atualizou as informações sobre a bactéria identificada na Unidade de Terapia Intensiva (UTI) neonatal. A bactéria foi identificada na quarta-feira (22). Não foram divulgados detalhes sobre a bactéria ou o número de pacientes afetados. A atualização das informações foi feita pelo hospital, que não forneceu mais informações sobre o caso. A identificação da bactéria é um procedimento comum em hospitais para garantir a segurança dos pacientes. No entanto, a falta de detalhes sobre a bactéria e o número de pacientes afetados pode gerar preocupação entre os familiares e os pacientes. O Hospital Fêmina é um dos principais hospitais de Porto Alegre e atende a uma grande quantidade de pacientes todos os anos.
Redação Jornal Expresso Regional
Imagens: Divulgação
